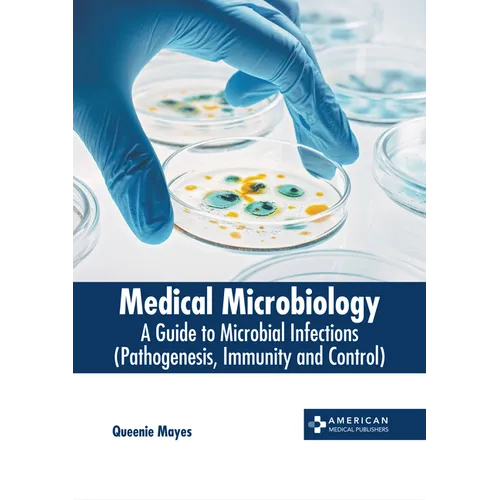
Medical Microbiology: A Guide to Microbial Infections (Pathogenesis, Immunity and Control) - Hardcover

by Queenie Mayes (Editor)
Medical microbiology refers to a sub discipline of microbiology which is applied in biology. The major aim of medical microbiology is the diagnosis, treatment and prevention of infectious diseases, which can be caused by microorganisms like viruses, bacteria, parasites and fungi. It is also focused on the study of different clinical applications of microbes for improving the health. Epidemiology is a significant aspect of medical microbiology, which investigates the causes, effect and patterns of health and disease. However, the clinical aspect is concerned with the microbial infections affecting the humans, and various methods for the treatment of infectious diseases. A detailed diagnosis of infectious disease comprises various techniques, such as genotyping, microbial culture, biochemical tests and microscopy. This book explores all the important aspects of medical microbiology in the present day scenario. Also included herein is a detailed explanation of pathogenesis, immunity and control of microbial infections. This book will serve as a reference to a broad spectrum of readers.
Number of Pages: 260
Dimensions: 0.63 x 11 x 8.5 IN
Publication Date: September 26, 2023